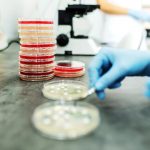
SemFYC plantea pruebas diagnósticas rápidas en AP en todo el país para frenar las RAM

España ha entrado oficialmente en fase epidémica de gripe, con una tasa de 40,1 casos por 100.000 habitantes en la última semana, según los últimos informes publicados por el Instituto de Salud Carlos III (ISCIII). Esta temporada atípica, impulsada por la nueva cepa subclade K del virus A(H3N2) –una variante más contagiosa que circula por Europa y encuentra menor inmunidad poblacional–, se ha adelantado un mes respecto a lo habitual, con un pico previsto entre mediados y finales de diciembre. Además, este repunte coincide en el tiempo con otras infecciones respiratorias (Covid-19 y Virus Respiratorio Sincitial).
El incremento de contagios ocasiona que cada vez más ciudadanos acudan a las farmacias, donde un profesional sanitario les recomendará un test con el que salir de dudas, algún medicamento para combatir los molestos síntomas causados por estos virus respiratorios o pueden adquirir mascarillas para hacer frente a esta epidemia estacional y proteger así tanto su salud como la del resto de la ciudadanía.
Si bien en tres de cada cuatro hogares españoles ya se depositan en el Punto Sigre de las farmacias los residuos de medicamentos (como por ejemplo, los antigripales), es normal que aún surja la pregunta de si, una vez usados, también se deben depositar los test de autodiagnóstico o las mascarillas en estos contenedores blancos que se encuentran en las propias farmacias. Para aclarar esta cuestión, desde Sigre se recuerda por qué no deben depositarse en el Punto Sigre.
Es importante recordar que Sigre es la entidad sin ánimo de lucro encargada de garantizar la correcta gestión medioambiental de los medicamentos caducados o no utilizados y sus envases que se generan en los hogares. Por tanto, los test de autodiagnóstico para la gripe o la Covid-19 o las mascarillas nunca deben desecharse en el Punto Sigre al no tratarse de medicamentos.
Estos productos deben desecharse en el cubo de la basura normal o fracción resto (bolsa de basura negra), donde van los residuos que no pueden ser reciclados. No obstante, se debe destacar que los envases donde vienen los test o las mascarillas sí deberán depositarse en el contenedor de recogida selectiva de envases correspondiente: azul para las cajas de cartón, amarillo para las bolsas de plástico, etc.
También Sigre recuerda que los antibióticos ayudan a tratar infecciones causadas por bacterias, pero no curan las infecciones por virus como la gripe o el resfriado. Además, el uso incorrecto de los antibióticos puede hacer que las bacterias se vuelvan resistentes frente a futuros tratamientos. En 2023, 24.582 personas fallecieron en España a causa de bacterias multirresistentes, según los últimos datos de la Sociedad Española de Enfermedades Infecciosas y Microbiología (SEIMC). Un estudio publicado en The Lancet apuntó que, si el panorama actual no variaba, la resistencia a los antibióticos podría matar en 25 años a 208 millones de personas. Así, se estima que para 2050 sea la primera causa de muerte en el planeta.
“Es comprensible que surjan dudas, pero debemos insistir: el Punto Sigre no es un contenedor para cualquier producto que hayamos adquirido en las farmacias. Solo debe utilizarse para medicamentos caducados o que ya no se necesitan y sus envases”, ha indicado Miguel Vega, director general de Sigre.

César Hernández, director general de Cartera y Farmacia del Ministerio de Sanidad:
Kilian Sánchez, secretario de Sanidad del PSOE y portavoz de la Comisión de Sanidad del Senado.:
Rocío Hernández, consejera de Salud de Andalucía:
Nicolás González Casares, eurodiputado de Socialistas & Demócratas (S&D - PSOE):
Juan José Pedreño, consejero de Salud de Murcia: